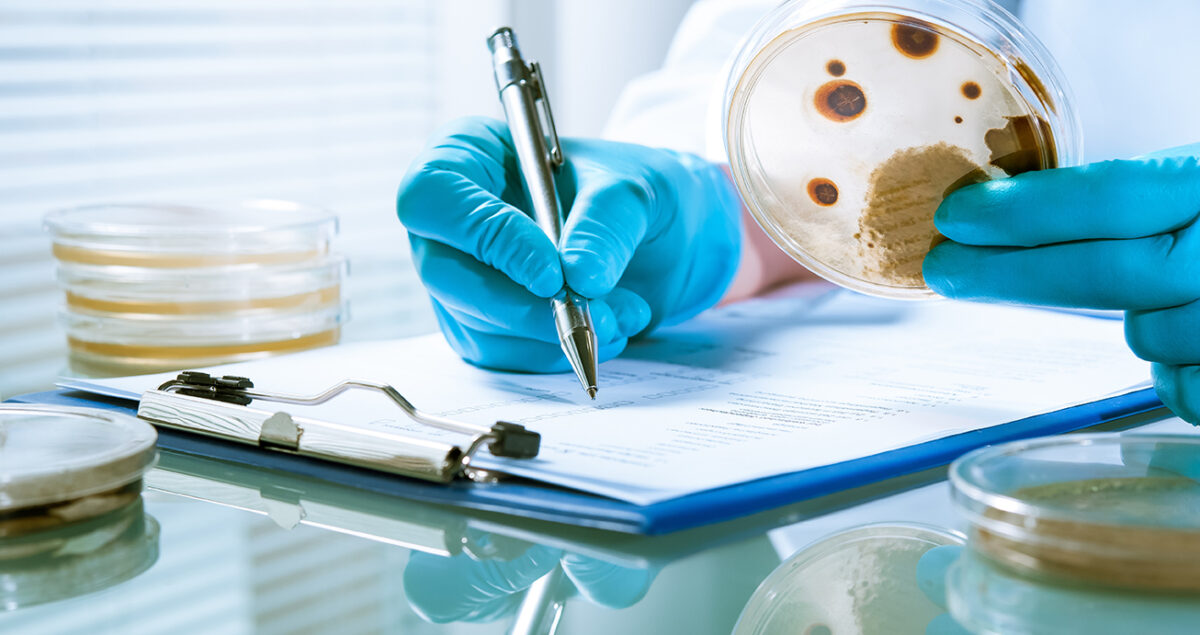
table de correction des resultats-alliance-bio-expertise

Qu’est-ce que c’est, à quoi ça sert ?
C’est la question que nous avons entendu lors de plusieurs visites client. Il y a en effet une différence entre les UFC
dénombrées, et le nombre réel de colonies présentes sur la boite impactée. C’est simple : plus le diamètre des trous de la grille est grand, plus la probabilité d’aspirer plusieurs bactéries et de les impacter au même endroit est forte.
Exemple : 2 bactéries aspirées par le même trou, ne donneront pas 2, mais 1 seule colonie !

Alors, comment évaluer le nombre réel de colonies ?
C’est l’intervention d’un savant calcul statistique issu des travaux de J.Maker qui vous permettra de le déduire. Et si comme nous, vous n’êtes pas très matheux, la plupart des échantillonneurs d’air sont fournis avec une grille de correspondance, disponible à la fin du manuel utilisateur.
Pourquoi est-ce important?
Un dénombrement conforme peut vite se transformer en niveau d’alerte ou d’action.

Comme vous pouvez le constater, ne pas utiliser la grille de correspondance peut avoir un impact important sur votre rendu de résultat. Mais rassurez-vous, plus les valeurs sont basses, moins l’écart est grand !
Qu’en est-il de mon échantillonneur d’air ?
Chaque type d’échantillonneur possède une grille différente : le nombre de trous et leur diamètre varie d’une
marque à l’autre. Ils ont donc chacun leur table de correction des résultats, bien souvent présente dans le manuel utilisateur.
Maintenant à vous de jouer !

Vous souhaitez en savoir plus sur notre gamme pour
les prélèvements d’air et des surfaces :
👉 Si vous avez la moindre question, ou si vous souhaitez plus d’informations sur nos préleveurs d’air, contactez-nous :
Contact :
« * » indique les champs nécessaires